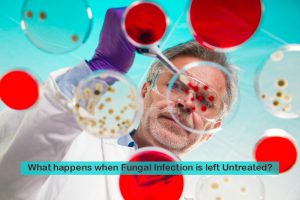
What happens when Fungal Infection is left Untreated? - Ciron Drugs Blog

what happens if you leave a fungal nail infection untreated Toenails nail discolored thickened done fungal infection discoloration result
As we all know, fungal nail infections can be annoying and embarrassing. They can cause your nails to become discolored, thick, cracked, and even emit an unpleasant odor. Fungal nail infections are contagious and can spread from one person to another or from one part of the body to another. Let us explore the causes, symptoms, and treatment options for fungal nail infections. Causes: Fungal nail infections are generally caused by fungi, yeasts, or molds. These fungi thrive in warm, moist environments, and can easily infect your nails if you’re exposed to them. Some of the most common causes include: 1. Walking barefoot in damp environments 2. Wearing tight-fitting shoes 3. Sharing nail clippers or other personal hygiene items 4. Poor circulation 5. Damaged nails Symptoms: Fungal nail infections are commonly confused with other conditions, such as psoriasis, eczema, or bacterial infections. Some of the most common symptoms of fungal nail infections are: 1. Thickened nails 2. Brittle or crumbling nails 3. Nails that are deformed or discolored 4. Foul-smelling nails 5. Nail separation from the nail bed Treatment Options: Fungal nail infections are treated with a variety of methods, including over-the-counter creams, prescription medications, and home remedies. Some of the most common treatment options include: 1. Antifungal creams or ointments 2. Oral antifungal medications 3. Laser therapy 4. Surgery It’s important to note that some of these treatments may have side effects, so it’s essential to speak with a healthcare professional before beginning any treatment. Prevention: Preventing fungal nail infections is essential to maintaining healthy nails. Some preventative measures you can take include: 1. Keeping your toenails and fingernails clean and dry 2. Wearing shoes that fit well and aren’t too tight 3. Avoid walking barefoot in public areas, such as swimming pools or locker rooms. 4. Refraining from sharing nail clippers or other grooming items 5. Keeping your hands and feet moisturized to prevent cracking. In conclusion, fungal nail infections can be annoying and embarrassing but know that they are a common condition that affects many people. If you suspect you have a fungal nail infection, consult a healthcare professional immediately. Take steps to prevent the occurrence of fungal nail infections in the first-place and be sure to maintain good nail hygiene to keep your nails looking happy and healthy.
If you are looking for What happens when Fungal Infection is left Untreated? - Ciron Drugs Blog you’ve visit to the right place. We have 5 Pics about What happens when Fungal Infection is left Untreated? - Ciron Drugs Blog like How To Stop Your Fungal Nail Infection Spreading Through Your Family, What happens when Fungal Infection is left Untreated? - Ciron Drugs Blog and also What happens when Fungal Infection is left Untreated? - Ciron Drugs Blog. Here it is:
What Happens When Fungal Infection Is Left Untreated? - Ciron Drugs Blog
www.cironpharma.comfungal kandida deri enfeksiyonu untreated nedir mantar mantarı
www.cironpharma.comfungal kandida deri enfeksiyonu untreated nedir mantar mantarı
Nail Fungal Treatment In Singapore | Dr Wong Soon Tee
 www.assuranceskin.comfungal
www.assuranceskin.comfungal
Nail Fungus Infection: Symptoms, Causes, Diagnosis And Treatment.
 lifebd8.blogspot.cominfection fungus
lifebd8.blogspot.cominfection fungus
What Can Be Done For Thickened, Discolored Toenails?

How To Stop Your Fungal Nail Infection Spreading Through Your Family
 cartwrightpodiatry.com.aufungal
cartwrightpodiatry.com.aufungal
What can be done for thickened, discolored toenails?. Nail fungus infection: symptoms, causes, diagnosis and treatment.. Nail fungal treatment in singapore